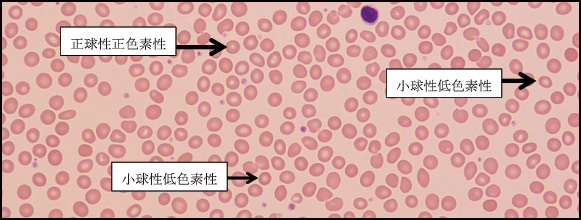

=== 新春随筆 ===
かくれ貧血:Silent Anemia
|
|
東区・郡元支部
(デイジークリニック) 武元 良整
|
|
2017年1月から「トランプ氏」が米国大統領就任。その原動力となったのが,「かくれ支持者」と報道されていることに驚きました。その支持者は英語表現では「I'm one of Trump's silent voters」となります。
一方で「かくれ貧血」という言葉をよく聞くようになりました。それは,貧血改善中でまだ低フェリチンの時期,またはこれから貧血に向かう時(貧血の始まりの時期にまずフェリチンが低下するため)の説明に使われます。外来での「Silent Anemia」診断のポイントについて紹介いたします。
定 義:「かくれ貧血」とはHb(血色素)が正常範囲。しかし,低フェリチン(12.0ng/mL未満)が認められる場合です。「潜在性鉄欠乏」と医学的に表現されます1)。
症 例:32歳,女性。
主 訴:倦怠感,たちくらみ,動悸,頭痛,夜中に吐き気。
背 景:5年目の不妊治療中(黄体不全),毎年しもやけあり。
病 歴:健診で正常(表1),TVで見聞きした「かくれ貧血」の検査を希望。
末梢血検査:来院時CBC(complete blood count:全血球計算)では貧血なし。図1の血液像では明らかな小球性低色素性赤血球を認め,赤血球の大小不同があります。赤血球の寿命が4カ月ですから図1の血液像は過去4カ月間の赤血球形態の一覧です。その形態から鉄欠乏状態があった事がわかります。貧血の回復期か?これから貧血へ向かうのか?の判断には網状赤血球%が有用です。
|
図1 末梢血液像:RBC形態は大小不同1+あり,多染性1+
(末梢血液画像は鹿児島市医師会臨床検査センター血液検査室へ依頼し撮影いただきました) |
検査結果
RBC:419万/μL,Hb:12.5g/dL,MCV (mean corpuscular volume:平均赤血球容積):89.0fL,MCH(mean corpuscular hemoglobin:平均赤血球血色素値):29.8pg,PLT(血小板数):19.3万/μL
臨床経過:血液生化学検査結果は,フェリチン低値(10.6ng/mL),血清ビタミンB12値は275pg/mL(基準値180-914)と軽度低値,葉酸値もやや低値,5.8ng/mL(基準値4以上)です。網状赤血球は0.9%(正常値1.0%)と低値でした。したがって,「潜在性鉄欠乏」の規定どおり,Hb>12.0と低フェリチン(12.0未満)から典型的なかくれ貧血でした。治療は鉄欠乏に対して鉄剤投与(鉄剤内服困難で静注)とビタミンB12静注。そして葉酸内服としました。
かくれ貧血は健診で見極める事ができる?:当院で過去1年間にHb値が12.0以上(貧血なし)かつ,フェリチン低下例(12.0ng/mL未満)は21例。その21例の中央値を表2に示します。これから見ても健診による「かくれ貧血」症例の見極めは困難と言えます。
まとめ
典型的なかくれ貧血は,通常の健診で「正常範囲」と判定されます。健診で貧血の指摘がないため診断は困難です。たとえば,「倦怠感・やる気が出ない・がんばれない・動悸・たちくらみ・食欲不振」などの臨床症状の訴えがあれば,フェリチン値を検査し,それが12.0未満であれば「かくれ貧血」と診断できます2)。
おわりに
かくれ貧血を診断する決め手は主訴にあります。なぜならHb値は表1と表2に示しますように正常値のため,貧血ではありません。倦怠感などの訴えに耳を傾け,フェリチン(貯蔵鉄)の検査を考慮する必要があります。
文 献
1.日本鉄バイオサイエンス学会治療指針作成委員会編:鉄剤の適正使用による貧血治療指針. 響文社,2009
2.武元良整:倦怠感・やる気がでない・がんばれない・動悸・時々たちくらみ・食欲不振,鹿児島市医報第55巻第10号(通巻656号):36-37,2016

|
このサイトの文章、画像などを許可なく保存、転載する事を禁止します。
(C)Kagoshima City Medical Association 2017 |